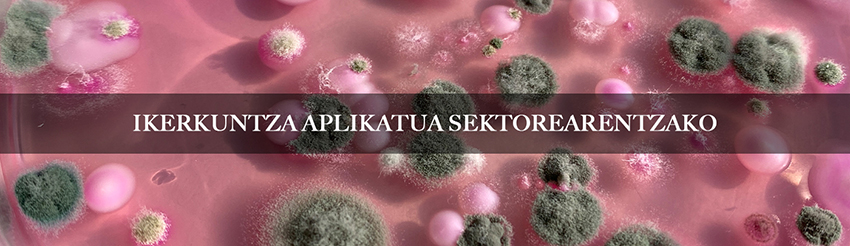

ESNEKI ZENTROA, ESNEKI SEKTOREAREN BIDELAGUN “Gure esnea, gure ekoizleak, gure osasuna”
Esneki Zentroa sektorearen garapen integralaren motorra da, berrikuntzaren eta aurrerabidearen erreferentea. Ikerketa aplikatua, produktu berritzaileen garapena eta ezagutza espezializatuaren transferentzia uztartuz, sektorearen erronkei eta beharrizanei erantzun eraginkorra ematen diegu. “Gure esnea, gure ekoizleak, gure osasuna” lelopean, gure helburua argia da, elkarrekin, esneki sektore indartsu, jasangarri eta lehiakor bat eraikitzea.
Azken urteetan, Euskal Herriko esneki sektoreak bilakaera esanguratsua izan du, artisau ereduan oinarritutako ekoizpenetik abiatuta, erronka berriei aurre egiteko gaitasuna erakutsiz.
Sektorea familia-unitateek kudeatzen dute nagusiki, eta %95etik gora mikro-gaztandegi ereduek osatzen dute. Ekoizleek, esne ekoizpena ez ezik, eraldaketa prozesuak ere beren gain hartzen dituzte, produktuei balio erantsia emateko eta merkatuan lehiakorrak izateko.
Hala ere, artisau ereduek hainbat erronka dakartzate: baliabide ekonomiko mugatuak, teknologia berrien ezarpen zaila, ezagutza teknologikoa eskuratzeko eta dibertsifikaziorako zailtasunak, eta abar. Horrez gain, araudi higieniko-sanitario zorrotzak eta merkaturatze prozesu konplexuak kudeatu behar izateak kanpo-aholkularitza teknologikoaren beharra areagotu du.
Erronka guzti horiei aurre egiteko eta 15 urteko ibilbidea egin ondoren 2021. urtean sortu zen ESNEKI ZENTROA marka gisa, Leartiker Zentro Teknologikoaren gidaritzapean, sektorearen beharrizanei erantzun jarraitzeko helburuarekin. Esneki Zentroaren xedea da esneki sektorea indartzea eta erreferente izatea, ikerketa, berrikuntza eta ezagutza teknikoa uztartuz, artisau ekoizpenaren kalitatea, segurtasuna, jasangarritasuna eta lehiakortasuna bultzatzeko.
Esneki Zentroan ikuspegi integralarekin egiten dugu lan, esnearen kalitatearen hobekuntzatik hasi eta esneki eta gazten merkaturatzeraino, prozesu guztietan esku hartuz. Esnekigile eta gaztandegien bidelagun gara, haien sorreratik egonkortze faseraino, esparru ezberdinetan ezagutza eta laguntza teknikoa eskainiz.
Azken urteetan, ikerkuntza lan garrantzitsuak garatu ditugu elikagaien segurtasunaren eta esnearen zein esnekien teknologiaren arloetan. Hauek dira nabarmendu daitezkeen ikerketa lan-lerro ezberdinak (https://esnekizentroa.eus/proiektuak/):
Elikagaien segurtasunarekin lotutako ikerkuntza:
Esne eta esnekien segurtasunarekin erlazionatutako arrisku mikrobiologiko eta kimikoen inguruko ikerketara bideratutako proiektuan garatu ditugu, besteak beste:
SHIGA: Shiga toxina sortzeko gaitasuna duten Escherichia Coli andui ezberdinen azterketa genetikoa.
ELAMINA-2: Elaborazioan eta heldutasunean proteolisi-gradu handiak dituzten gaztetan dauden amina biogenoak ezabatzeko estrategiak baloratzea.
EZtaphTox: Elikagaietan S. aureus-en enterotoxinak ekoiztea eragiten duten faktore eta gen erregulatzaileak.
GAZTANOLA: Gazten afinazioan egurrezko apalak erabili ahal izateko eskaera-prozesuan aplika daitezkeen ebidentziak lortzera begira bideraturiko ikerketa.
Esnearen gaitasun teknologikoaren ikerkuntza:
Esnearen ezaugarri mikrobiologiko eta fisiko-kimikoen inguruko ikerkuntza egiten dugu, esneak gaztagintzarako duen gaitasun teknologikoa aztertuz eta ekoizpen-prozesuen egokitzapena burutuz kalitate bereizgarriko gaztak garatzeko helburuarekin. Azken urteetan ondorengo proiektuak garatu ditugu esparru honetan, besteak beste:
MILKSUIT: Gaztagintzarako egokia den esnearen ekoizpenerako abereen elikadura eta kudeaketa praktikak egokitzea.
DAIRITAL: Ekoizpen-sistema jasangarriak garatzea SUDOE eremuko esnegintza-sektore tradizionalean.
ESNEKAL: Ardi- eta ahuntz-esne gordinaren kalitate mikrobiologikoa eta proteikoa aztertzea, gaztagintzan arazo teknologikoak saihesteko.
PROTEBAL: Esne gordinaren proteina-frakzioaren eta flora laktiko indigenaren azterketa, EAEko artisau-gaztandegietako kalitate eta tipikotasunaren faktore gisa.
Esneki eta gaztagintza teknologia eta afinazio tekniken inguruko ikerkuntza:
Esneki eta gazta familia bakoitzaren ekoizpen prozesuan eragiten duten parametro teknologiko eta gazten afinazio teknika ezberdinen inguruko ikerketa barneratzen duten proiektuak garatzen ditugu, besteak beste:
BEHITEK: Kalitate goreneko behi esnedun gazta berritzaileen garapena.
ONDTEK: Ardi gazta onduaren ekoizpen prozesuaren balioztatzea, erreferentziazko balio fisiko-kimikoen parametrizazioaren bidez.
GAZTAKAL: Gazta familia bakoitzaren elaborazio prozesuko parametro teknologikoak aztertzea, elaborazio- eta fintze-prozesuaren kalitate-kontrol gisa.
BLUECARE: Zenbakizko teknologiak eta sentsore bidezko teknologia sartzea kalitate organoleptiko bereiziko gazta urdin seguru, osasungarri eta jasangarriaren ekoizpena eta afinazioa kontrolatzeko.
Garatutako proiektu ezberdinen emaitzak sektoreko eragileei transferitu zaizkie hainbat kanalen bidez, besteak beste, prestakuntza saioak, aholkularitza teknikoa eta dokumentazio espezializatua erabiliz. Transferentzia prozesu horren bidez, ikerkuntzaren emaitzak praktikara eraman dira, sektorearen eguneroko jardunean eragina izateko helburuarekin. Bestalde, elikagaien segurtasunarekin lotutako ikerkuntza-proiektuak Elika fundazioarekin eta Eusko Jaurlaritzako Elikagaien Segurtasun Mahaiarekin lankidetza estuan garatu dira, sektorearen beharrei erantzun eraginkorra eta koordinatua eskaintzeko.
Sektorearen beharrei erantzuteko ikerketa aplikatua garatzeaz gain, beste jarduera-esparru garrantzitsu batzuetan ere dihardugu, sektorearen garapen integrala sustatzeko helburuarekin.

Gaztandegiei egunerokotasunean laguntzen diegu, etengabeko aholkularitzaren bidez, elaborazio-prozesuetan, indarrean dauden higiene- eta osasun-araudiak aplikatzen eta etiketak kontsumitzailearentzako informazioari buruzko araudira egokitzen. Gure zerbitzuak honako hauek barne hartzen ditu:
- Gaztandegi berri baten sorrerarako aholkularitza: espazioaren diseinua, ekipamendu beharrak eta Osasun Sailarekin bitartekaritza.
- Elaborazio prozesuen egokitzapen eta optimizazioa.
- Gazten ekoizpenean sor daitezkeen akatsen identifikazioa eta hauek ekiditeko egokitzapenak.
- Elikagaien segurtasunaren kudeaketa.
- Autokontrol planen garapena, ezarpena eta urteko jarraipena.
- Osasun Sailaren auditorien osteko ekintza planen definizioa.
- Esne, esneki zein gainazalen analisiak eta hauen interpretazioa
- Intzidentzien aurrean aholkularitza eta neurri zuzentzaileen ezarpena.

Esneki sektoreari zuzendutako prestakuntza espezializatua eskaintzen dugu, ekoizleen gaitasun teknikoa eta ezagutza sakontzeko helburuarekin. Gure formakuntza-eskaintza honako arlo hauek hartzen ditu:
- Esne eta esnekien kalitatea
- Gaztagintza teknologiara lehen hurbilpena
- Esneki fresko ezberdinen elaborazioa
- Gazta kategoria ezberdinen elaborazioa
- Gazten afinazioa (MONS Formation-ekin lankidetzan)
- Gazten merkaturatzea (MONS Formation-ekin lankidetzan)
- MONS Experience (MONS Formation-ekin lankidetzan)
Esneki sektoreak erronka ugari ditu aurretik, baina baita aukera paregabeak ere. Artisau ereduan oinarritutako ekoizpenak bereizgarritasuna eta kalitatea eskaintzen ditu, eta sektoreko eragileek eguneroko lanarekin erakusten dute berrikuntzarako eta hobekuntzarako duten gaitasuna.
Esneki Zentroa hemen da, sektorearen garapenerako bidelagun teknologiko gisa. Elkarrekin, berrikuntza, ezagutza eta kalitatea uztartuz, esneki sektore indartsu, jasangarria eta lehiakor bat eraikitzen jarraituko dugu.